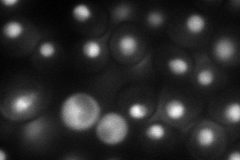
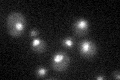

View description
Putative catalytic subunit of a class II histone deacetylase complex that also contains Hda2p and Hda3p; Hda1p interacts with the Hda2p-Hda3p subcomplex to form an active tetramer; deletion increases histone H2B, H3 and H4 acetylation
Localization:
Intensity:
Fold change:
Significance:
-
C’ GFP library in SD

nucleus33.47 -
N' NOP1pr-GFP in SD
nucleus,nucleolus100.023 -
N' TEF2pr-mCherry in SD

below threshold0 -
N' NATIVEpr-GFP in SD

nucleus24.5587 -
N' TEF2pr-VC and Cyto-VN in SD

nucleus40.1505 -
C’ GFP library in SD+DTT

nucleusN/AN/ANo -
C’ GFP library in SD+H2O2

nucleusN/AN/ANo -
C’ GFP library in Starvation Media
nucleusN/AN/AYes -
C’ GFP library on the background of Pup2-DaMP

nucleus -
C’ GFP library on the background of CCT mutant

nucleusN/AN/ANo
